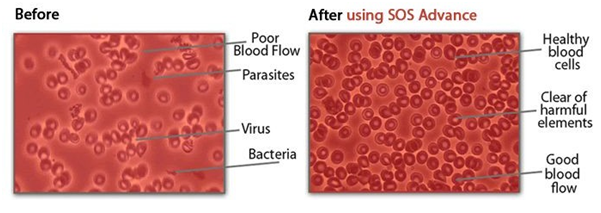

SOS Advance Capsules
₦ ?70,000
Get Latest Prices From Yello.NG So You Can Sello.NG Better
₦ ?70,000
Get Latest Prices From Yello.NG So You Can Sello.NG Better

Typically replies within an hour
I will be back soon